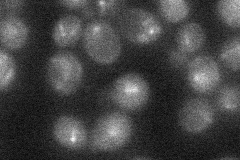
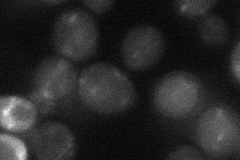

View description
Subunit of the conserved chromosomal passenger complex (CPC; Ipl1p-Sli15p-Bir1p-Nbl1p), which regulates kinetochore-microtubule attachments, activation of the spindle tension checkpoint, and mitotic spindle disassembly
Localization:
Intensity:
Fold change:
Significance:
-
C’ GFP library in SD

below threshold16.61 -
N' NOP1pr-GFP in SD

punctate35.3151 -
N' TEF2pr-mCherry in SD

punctate11.4938 -
N' NATIVEpr-GFP in SD
punctate22.3466 -
N' TEF2pr-VC and Cyto-VN in SD
below threshold26.2485 -
C’ GFP library in SD+DTT

cytosol18.031.08No -
C’ GFP library in SD+H2O2

cytosol19.221.15No -
C’ GFP library in Starvation Media

cytosol15.570.93No -
C’ GFP library on the background of Pup2-DaMP

below threshold -
C’ GFP library on the background of CCT mutant

below threshold18.39071.10657No
